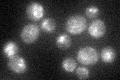
YLR386W
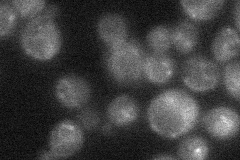
YLR386W

View description
Protein involved in regulated synthesis of PtdIns(3,5)P(2), in control of trafficking of some proteins to the vacuole lumen via the MVB, and in maintenance of vacuole size and acidity; interacts with Fig4p; activator of Fab1p
Localization:
Intensity:
Fold change:
Significance:
-
C’ GFP library in SD
vacuole membrane31.77 -
N' NOP1pr-GFP in SD

mitochondria86.0236 -
N' TEF2pr-mCherry in SD

punctate87.0704 -
N' NATIVEpr-GFP in SD
punctate24.6604 -
N' TEF2pr-VC and Cyto-VN in SD

cytosol49.698 -
C’ GFP library in SD+DTT

vacuole membrane32.261.01No -
C’ GFP library in SD+H2O2

vacuole membrane32.821.03No -
C’ GFP library in Starvation Media

vacuole membrane37.851.19No -
C’ GFP library on the background of Pup2-DaMP

vacuole membrane -
C’ GFP library on the background of CCT mutant

vacuole membrane38.23941.20331No
